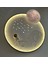

EOS Aydınlatma Astronot Ledli Kumandalı Tavan Avizesi 3 Işık Renk Tonu (Sarı, Beyaz ve Günışığı) Kumanda Ile Gece Modua
Ürün Bilgileri
Astronot Ledli Kumandalı Tavan Avizesi 3 Işık Renk Tonu (Sarı, Beyaz ve Günışığı) Kumanda Ile Gece Modua
- 👨🚀 Astronot LED’li Kumandalı Tavan Avizesi – 3 Işık Renk Tonu (Sarı, Beyaz, Günışığı) | 48W | Çap: 50 cm
- Hayaller gökyüzüne kadar çıkmazsa, yıldızlara dokunmak mümkün mü?
- Astronot LED’li Kumandalı Avize, minik kaşifler ve uzay tutkunları için tasarlanmış eşsiz bir aydınlatma deneyimi sunuyor. Ay yüzeyinde oturan sevimli astronot figürü ve 3D gezegen tasarımıyla hem eğlenceli hem de dekoratif bir çözüm.
- 🚀 Ürün Özellikleri:
-
3 Farklı Işık Renk Tonu: Kumanda ile kolayca geçiş yapılabilen sarı, beyaz ve günışığı aydınlatma seçenekleriyle odanıza dilediğiniz ambiyansı kazandırın.
-
Gece Modu: Özellikle çocuk odaları için ideal olan yumuşak gece ışığı, huzurlu bir uyku ortamı sunar.
-
48 Watt LED Güç: Enerji verimliliği sağlayan güçlü ışık sistemiyle hem ekonomik hem etkili aydınlatma.
-
Astronot Temalı 3D Tasarım: Ay yüzeyi dokusu, yıldız ve meteor figürleriyle detaylandırılmış arka plan ve dev 3D gezegen topu ile gerçek bir uzay macerası!
-
Uzaktan Kumanda ile Kontrol: Aç/kapat, renk değiştirme ve gece modunu zahmetsizce kontrol edin.
-
Dekoratif ve Fonksiyonel: Çocuk odası, genç odası ya da hayal gücüne değer veren her yaşam alanı için harika bir tercih.
- 📐 Teknik Detaylar:
-
Güç: 48 Watt
-
Işık Tonları: Sarı, Beyaz, Günışığı
-
Kontrol: Uzaktan Kumanda
-
Tasarım: Astronot – Ay Yüzeyi & 3D Gezegen Topu
-
Çap: 50 cm
-
Kullanım Alanı: Tavan Montajlı
- Evde bir uzay üssü kurmaya hazır mısınız?
Astronot LED Avize, çocukların hayal dünyasını zenginleştirirken, estetik görünümüyle dekorasyonun yıldızı oluyor! - 🛒 Şimdi sipariş verin, evinizdeki küçük astronotlara gökyüzünü hediye edin!